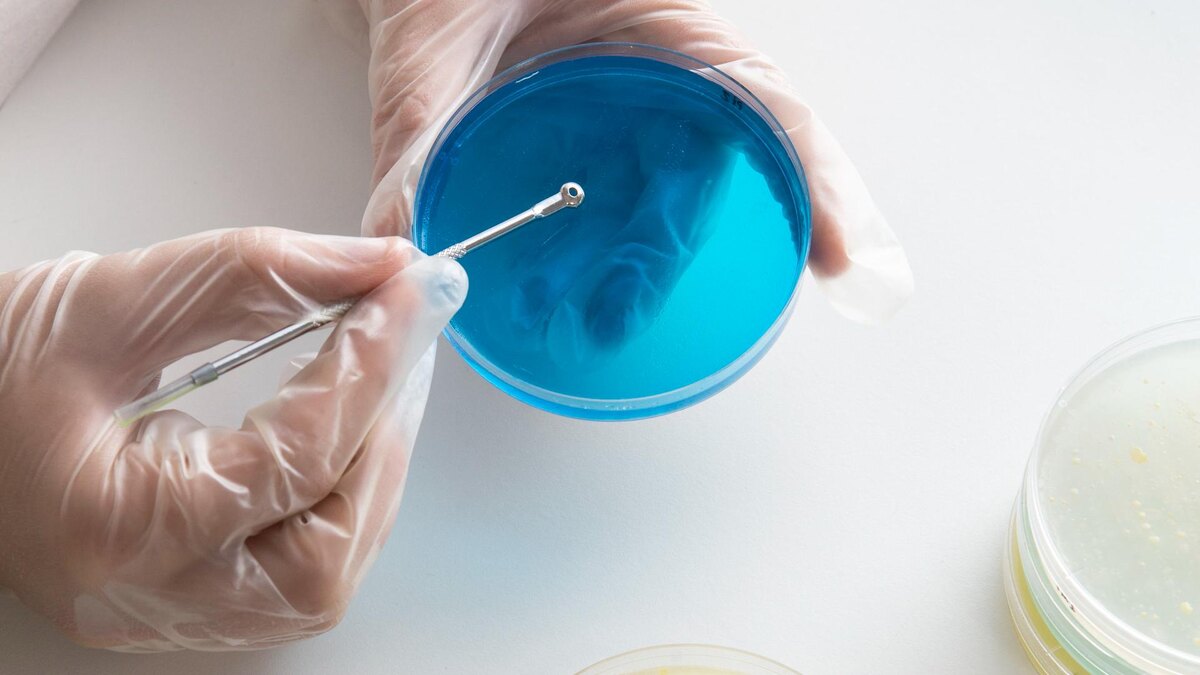

Недавнее расследование вскрыло серьезные проблемы в московских ресторанах сети True Cost, известной своими "честными ценами". Несмотря на популярность, связанная с доступностью меню, результаты проверок оставляют желать лучшего.
Обращения потребителей не на шутку насторожили
Редакция проекта «SHOT ПРОВЕРКА» получила множество жалоб и отзывов от клиентов на низкое качество обслуживания в ресторанах сети. Посетители сообщали о плохом самочувствии после посещения, а две девушки заявили, что отравились после обеда. Все попытки связаться с администрацией оказались тщетными, что вызвало еще больше вопросов.
Проверка выявила серьезные нарушения
Вместе с экспертом по пищевой безопасности Ольгой Пасько журналисты провели обследование нескольких ресторанов сети. Результаты оказались шокирующими: неупакованные продукты, грязные овощи и неправильно хранившиеся мидии — лишь часть из списка нарушений. Также отмечено пренебрежительное отношение персонала к требованиям гигиены.
Экспертная проверка Федерального исследовательского центра питания подтвердило худшие опасения — в тартаре из говядины и салате оливье были зафиксированы повышенные уровни кишечной палочки. Эти блюда были признаны потенциально опасными для здоровья клиентов.
Задумайтесь о возможных нарушениях
Кроме того, исследование показало, что сеть True Cost раздробила свои юридические лица на несколько компаний. Это открывает вопросы о финансовой прозрачности бизнеса. В одном из ресторанов официально числятся лишь три сотрудника, что предполагает потенциальные нарушения трудового законодательства.
Результаты проверки были отправлены в соответствующие надзорные органы для дальнейшего разбирательства.
Ранее сообщалось, что прокуратура Петербурга начала расследование массового отравления учеников и сотрудников одной из школ в Невском районе.